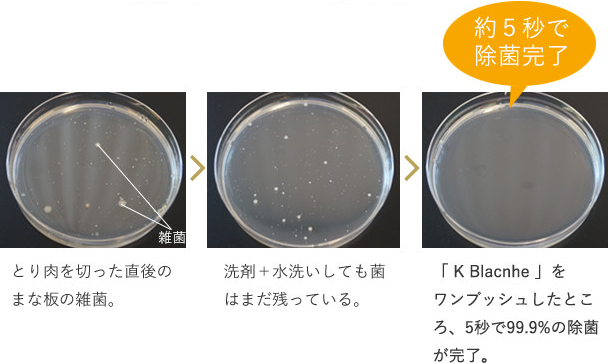

キッチンや浴室って丁寧に掃除したものの本当にキレイになったか信用がおけないなんて思っていませんか?
私は、掃除だけでは菌が落ちるとは思えず、子供が舐めたりしないかとても心配になることがあります。
そんな時に出会ったのが、無敵除菌のスプレーです。
[
題目通りのこちらK Blanche卵の力のロコミは?キューピーが無敵の除菌スプレーを発売です。
K Blancheロコミや評判は?卵のキューピーがウイルス除菌!アレルギーもというテーマで進めていきます。
K Blanche(ケイブランシュ)無敵の除菌スプレーってあるの?
キューピーから当所したタマゴの力をつかった除菌スプレーです。
キューピーが開発したというだけでも、興味があるのではと思いますが、なぜタマゴなの??というのも興味がありませんか?

実話、タマゴというのはとても除菌成分が高い成分で出来ています。
え?なんで??って思いますよね。
私個人的には、タマゴなんて菌が多そうというイメージだったのでびっくりしました。
意外としられていませんが、ゆで卵と生卵ってどちらが長持ちすると思いますか??
タマゴというだけでどちらも長持ちしないのでは?と思いますよね。
そのひみつは、公式サイトにありますので気になる方はこちらからどうぞ
K Blanche(ケイブランシュ)は、卵アレルギーでも大丈夫?
結論から言うと、卵アレルギーの方にも安心して使用いただけます。
あくまでもちょくせつのたまごというわけではないので、除菌パワーの部分のみたまご成分をつかっています。
K Blanche(ケイブランシュ)の口コミや評判は?
値段が高いので購入に悩んでいましたが、今までの除菌スプレーとは全然違って今では他のスプレーに戻れなくなってしまったw
子供がなんでも口にいれてしまうので、口に入っても安全な除菌効果のあるものを探していた。卵から出来ているといいう安心感がとても大きい。
o-157に効くから食中毒対策として使っている。洗い終わったまな板や、食器にもひとかけして簡単除菌で助かっっている。
K Blanche(ケイブランシュ)は、「ノロクリアプロテイン」の開発に成功
タマゴの力というのには、このノロクリアプロテインです。
アルコールでの除菌でももちろん菌は減りますが、このノロクリアプロテインによりとても危ないとされる鶏肉の菌にも徹底した力をみせます。
除菌スプレーをさっと5秒かけるだけで菌が消え去ります。すごい!!!
抗ウイルス成分なので、安全、安心です。
小さなお子様がいるご家庭でも安全に使用していただけます。
また、お店を経営されている方には、食品の衛生問題は重大問題だと思います。
100%食品由来の成分なので、口に入るものにも安心して使用できます。
受験生、赤ちゃん、幼稚園児、スポーツ選手、サービス業など変な菌に侵されたら絶対にこまるぞ!という方には必須のアイテムではないでしょうか。
雑菌、バイ菌、臭い、お弁当箱、水筒、まな板、哺乳瓶など除菌って大変ですよね。
おもちゃにもシュッシュとかけちゃいましょう。
気心しれたママ友なんかにプレゼントにも最適です。

K Blanche(ケイブランシュ)やアルコールスプレーとの他社との除菌比較
吹きかけて5秒で99.9%のウイルス・細菌を除去できる事を確認されています。
これってすごいですよね。
キッチンのインテリア キユーピーのオシャレな除菌スプレーですし、塩素系の消毒剤ではないというのがいいところですね。
K Blanche(ケイブランシュ)はどこで買えるの?
公式サイトからが一番てっとりばやいですね。
とくにまとめ買いを希望される方には、特典もあるので気になる方は覗いてみてください。
ただ、言えるのはwドラッグストアーなどのアルコール除菌スプレーのほうが安いということ(*_*)
でも、ケイブランシェでなければ安心できない!という方が続出のためメディアでも話題となっているので、お高くても売れている現状です。
やっぱり安心できるものをお子さんのためにも使いたいのがママの心ですよね。
まとめ
K Blancheロコミや評判は?卵のキューピーがウイルス除菌!アレルギーもということでまとめてみましたが、小さなお子様のおられる家庭には安心できる除菌スプレーとして話題になっています。
アレルギーのある方にも安心して使える点がいいですね。

